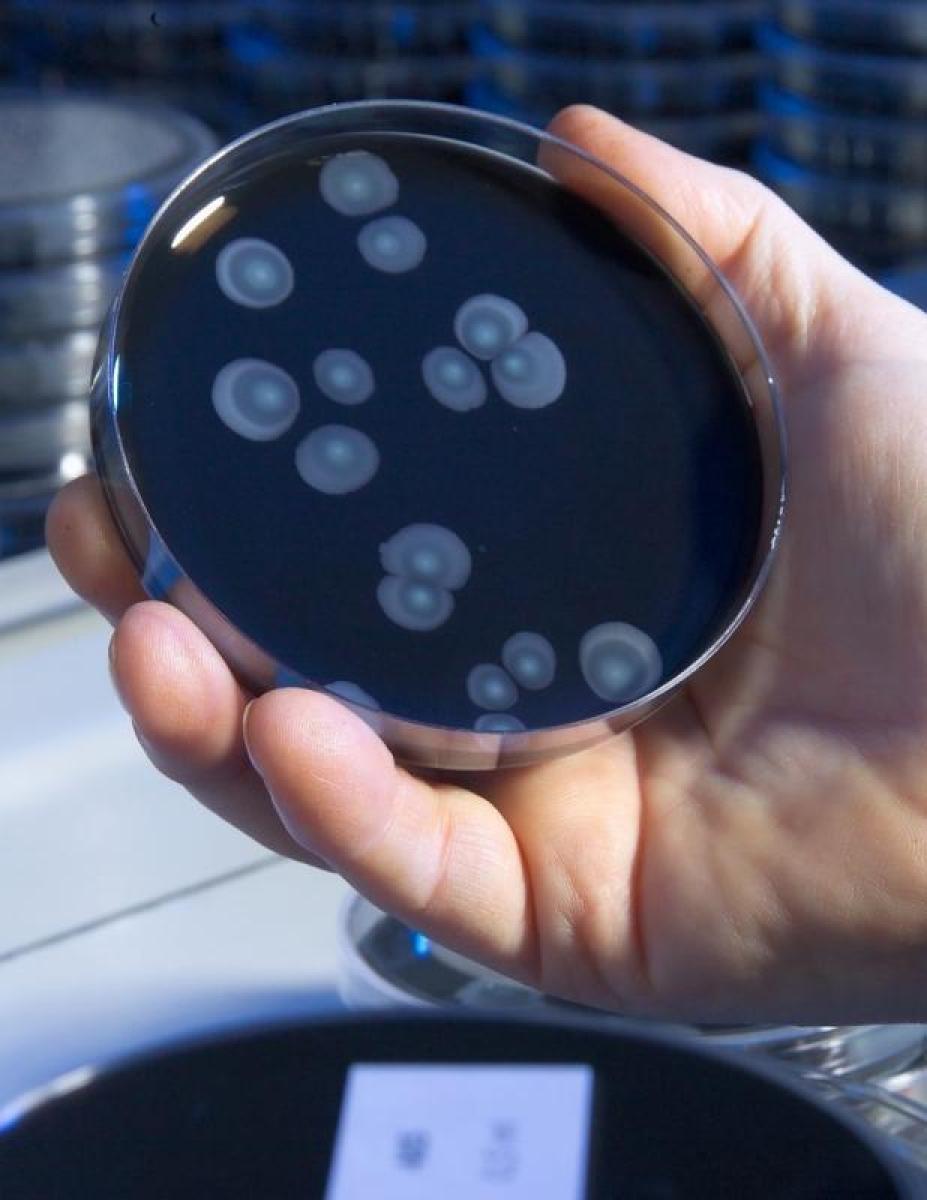

Das Vorkommen von Legionellen
Legionellen gehören zu den fakultativ pathogenen Bakterien und sind ubiquitär in fast allen aquatischen Biotopen (z. B. Grund- und Oberflächenwässer, Flüsse und Seen, Schlämme, heiße Quellen) zu finden. In natürlichen Wässern kommen Legionellen nur selten bzw. nur in sehr geringen Konzentrationen vor. Im Gegensatz dazu können sich diese Bakterien bei geeigneten Vermehrungsbedingungen in wasserführenden technischen Anlagen, wie z. B. in Trinkwasser-Installation (warm und kalt), Notduschanlagen, raumlufttechnischen Anlagen, Verdunstungskühlanlagen, Prozesswasserkreisläufen, Dentaleinheiten, Whirlpools, Springbrunnen, Scheibenwischanlagen, Waschstraßen u.a., sehr gut vermehren. Infektionsquellen für Legionellenerkrankungen beim Menschen liegen deshalb überwiegend im technisch-konditionierten Umfeld. Der Infektionsweg findet überwiegend, jedoch nicht ausschließlich, über die Aufnahme von kontaminierten Aerosolen (kleinste Wassertröpfchen in der Luft gelöst) statt.
Das Infektionsrisiko durch Legionellen
Bei den durch Legionellen verursachten Infektionserkrankungen handelt es sich am häufigsten um eine Legionella-Pneumonie / Legionellose (Lungenentzündung) oder das so genannte Pontiac-Fieber, eine grippeähnliche Erkrankung der Atemwege (siehe www.rki.de). Für diese Erkrankungen besteht gemäß Infektionsschutzgesetz (IfSG) eine Meldepflicht an das zuständige Gesundheitsamt.
Der Zusammenhang zwischen der Legionellenbesiedlung von wasserführenden technischen Anlagen, die oftmals gute ökologische Voraussetzungen für die Vermehrung von Legionellen bieten, und dem Auftreten von epidemischen Legionelleninfektionen ist durch eine Vielzahl von Untersuchungen belegt. Die Beachtung und Umsetzung der allgemein anerkannten Regeln der Technik (a.a.R.d.T.) beim Planen, Errichten und Instandhalten sowie der bestimmungsgemäße Betrieb, d.h. auch ausreichende Nutzung, von wasserführende technische Anlagen sind von großer Bedeutung bei der Minimierung eines Infektionsrisikos durch Legionellen.
Untersuchungen auf Legionellen
Durch technische Inspektionen und hygienisch-mikrobiologische Kontrollen potentieller Infektionsquellen lässt sich das Infektionsrisiko durch Legionellen einschätzen und durch die Sanierung von belasteten Anlagen beträchtlich vermindern. Sowohl bei einer telefonischen Beratung als auch bei einer Begehung vor Ort wird der Untersuchungsumfang mit der Probenahme und der Analytik für die jeweilige wasserführende technische Anlage festgelegt.
Auf Grundlage der gewonnenen Erkenntnisse, der Analysenergebnisse und unserer langjährigen Erfahrung werden ein mögliches Infektionsrisiko durch Legionellen abgeschätzt, der notwendige Handlungsbedarf ermittelt, Maßnahmen vorgeschlagen, technische Schwachstellen benannt, Sanierungskonzepte erarbeitet sowie Gefährdungsanalysen nach TrinkwV und Hygienegutachten erstellt.
Wir bestimmen Legionellen in Wasser aus
- Wasserversorgungsanlagen nach TrinkwV
- Trinkwasser-Installationen (kalt + warm)
- Augen- und Körperduschanlagen
- Dentaleinheiten und Ohrspülanlagen sowie anderen medizinischen Geräten
- leitungsgebundenen Trinkbrunnen und Wasserspendern
- Aufbereitungs-, VE- und Osmoseanlagen
- Prozesswasseranlagen
- Springbrunnen und anderen wasserführenden Anlagen mit Aerosolbildung
- Geräten und Apparaten in technischen Anlagen
- Kläranlagen
- Schwimmbeckenwasser-Aufbereitungsanlagen
- Raumlufttechnische Anlagen (RLT-Anlagen)
- Verdunstungskühlanlagen und Kühltürmen